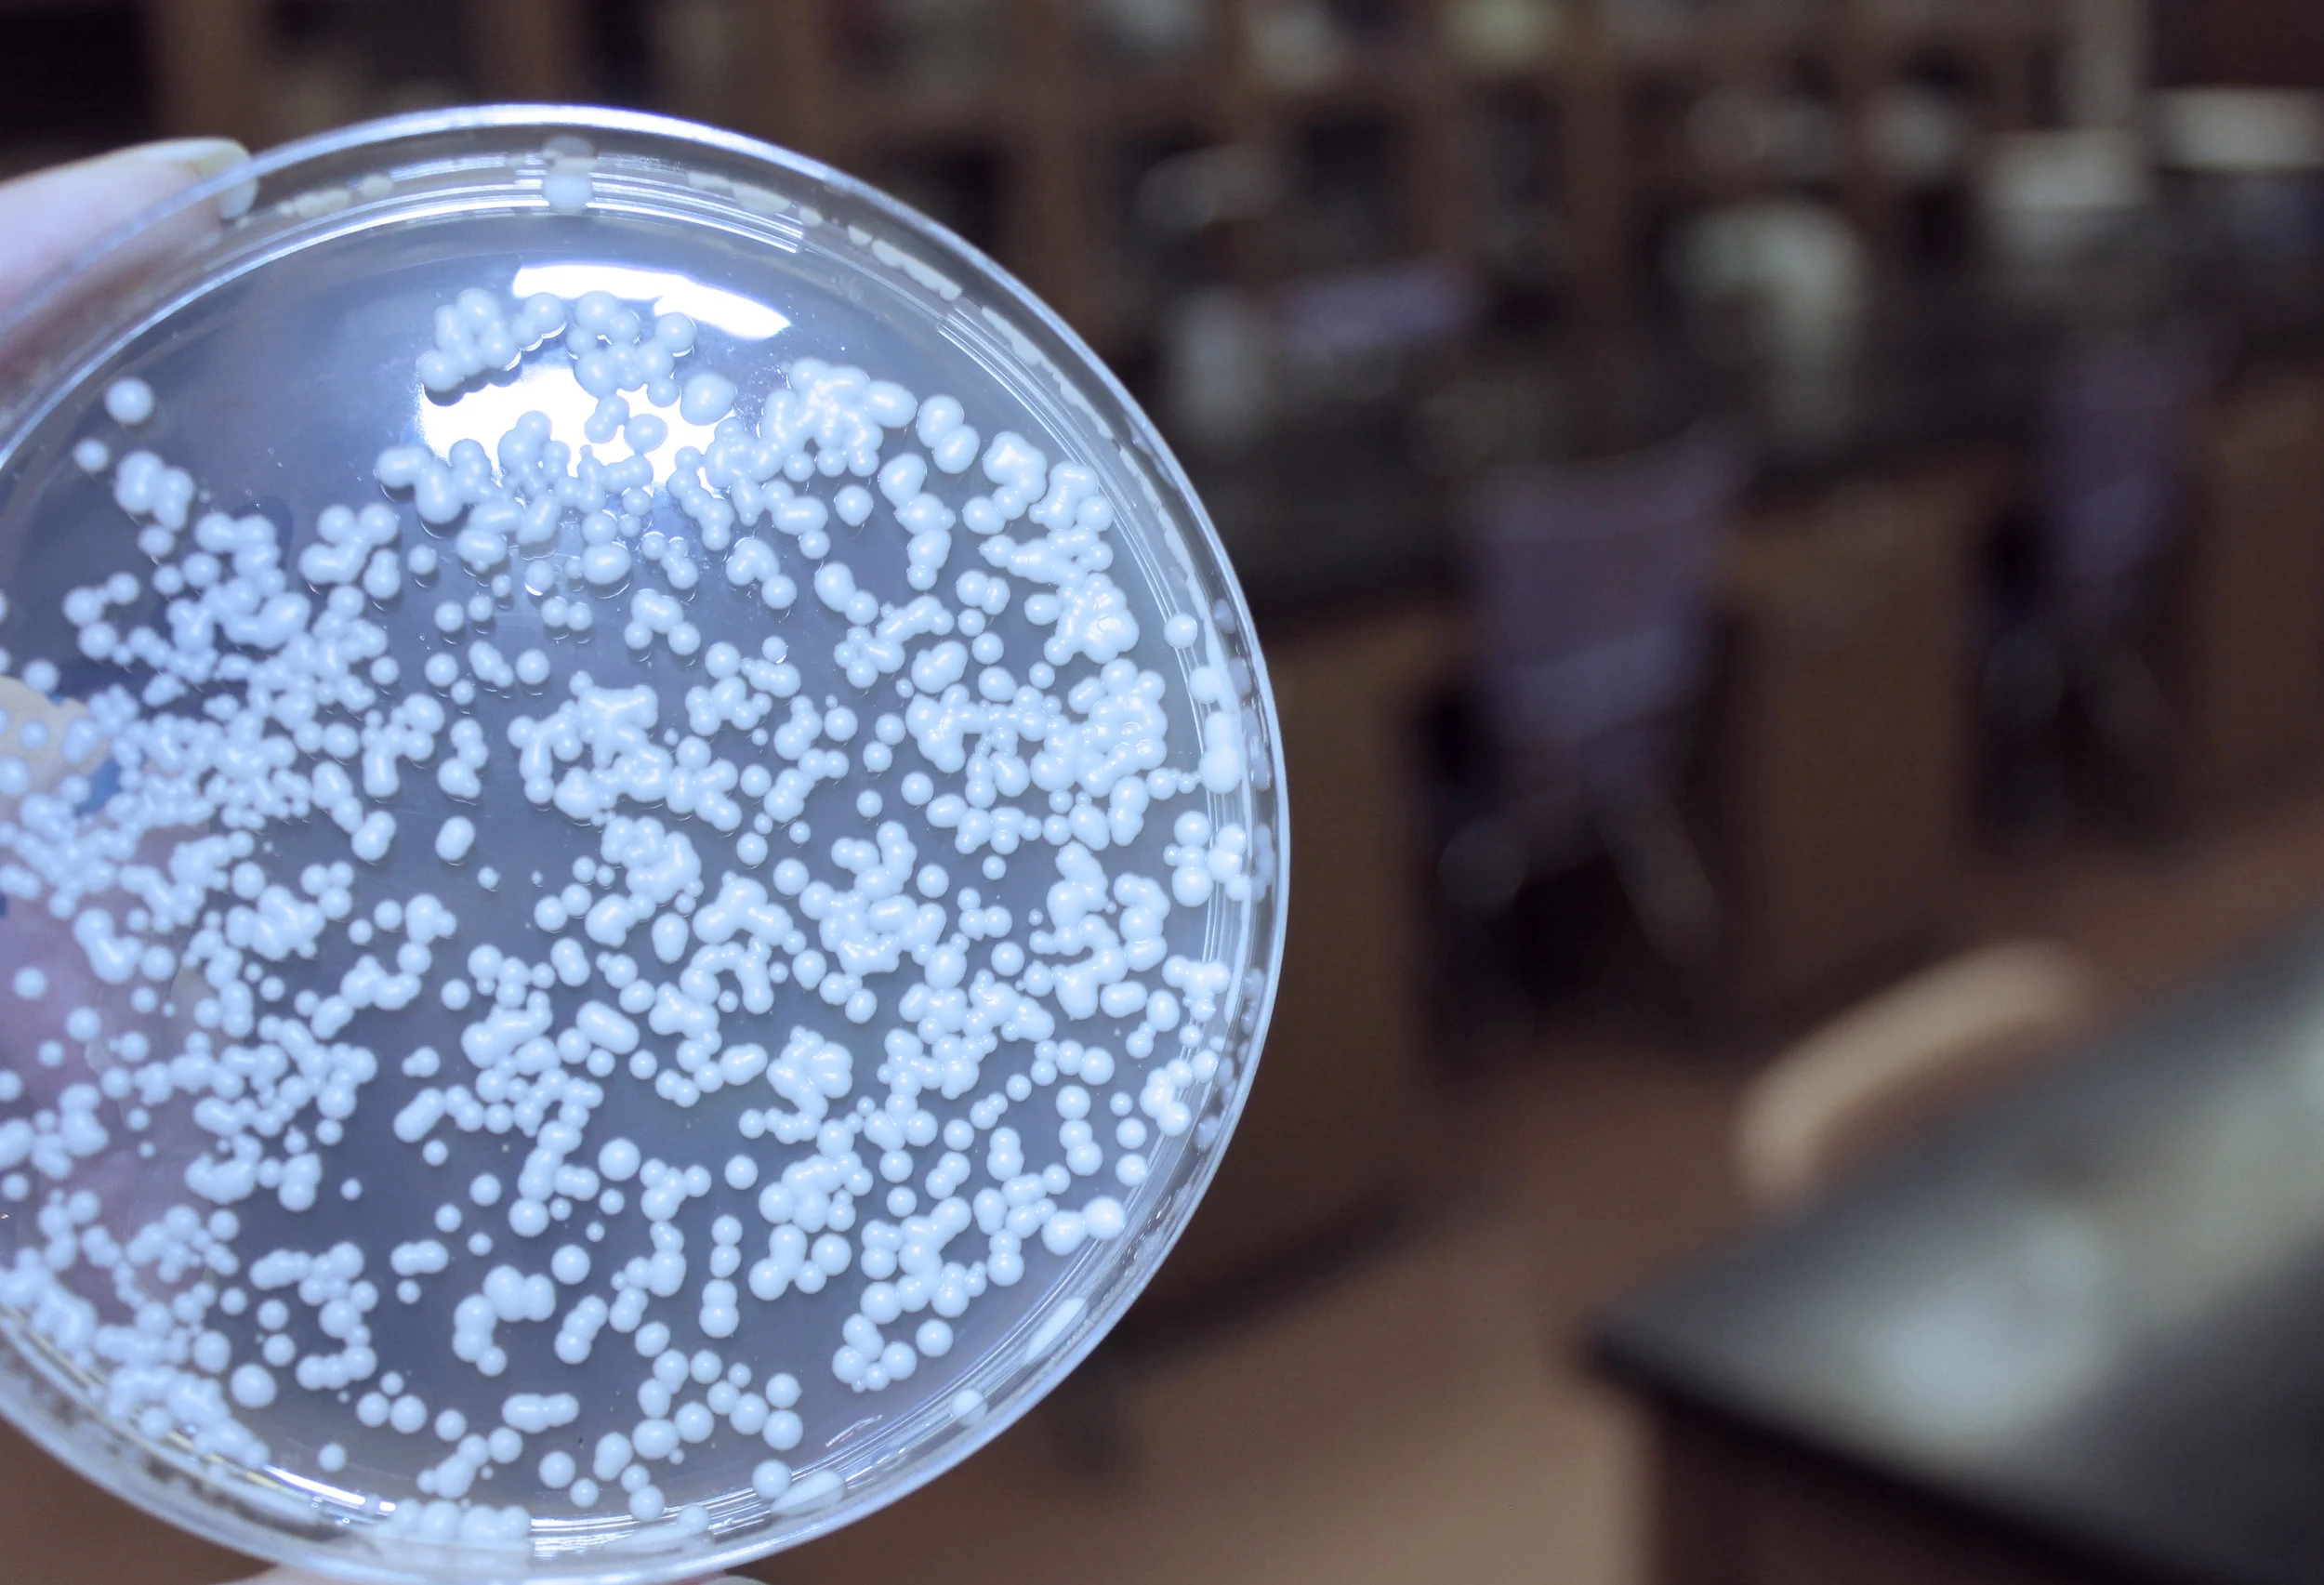

Saccharomyces cerevisiae (commonly known as Baker's Yeast)
Middle School Programming
Things get really interesting now. Our middle school programming is not just another science workshop. We explore the world through the lens of science. Everything is fair game: Food, medicine, sports, music...you name it. During workshops that are designed to be age appropriate specifically for students 10-15 years old, we focus on sustainability, do-it-yourself sufficiency, inventiveness and problem solving. We utilize top-notch, cutting edge equipment and technology to help our students explore what is going on at the forefront of modern science and to learn how science can be used to overcome everyday challenges and in extraordinary situations.
What will we be doing, you ask?
A Few of our middle school labs include:
Neuroscience and bioelectricity: Examine how organisms generate and use electrical energy. Apply these ideas by controlling another person's movements with your brain and constructing and operating a real cyborg beetle! It's not brain surgery...But it's close!
Extractions and Green Chemistry: Many of the chemicals we use every day, from perfumes to medicines, are extracted from nature. We learn how chemists separate specific compounds and apply cutting-edge techniques to isolate desired chemicals from organic matter in ways that do not produce harmful waste products.
Heat and Thermodynamics: Heat is energy and we can harness and use heat energy in all sorts of interesting ways. Students will apply these principles in ways such as learning techniques for starting a fire in a survival situation and to construct and operate a small engine.
Solar Energy: The sun is the ultimate source of energy for our planet. Here, we dig deep into the ways humans can harness the energy of the sun, from cooking with solar heat, to generating electricity by constructing solar cells with fruit juice. If plants can use solar energy, so can we!